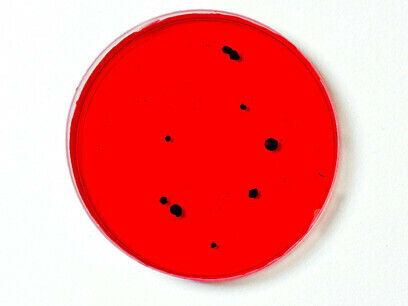
Im Labor: Nahaufnahme einer medizinischen Probe

Der menschliche Körper ist ein Ökosystem, das nicht nur eukaryotische Zellen (manchmal einfach menschliche Zellen genannt), sondern auch Bakterien und Archaeen (prokaryotische Zellen) sowie Viren, Pilze, Hefen und Protozoen enthält1-2. Tatsächlich enthalten die Bakterien in unserem Darm weitaus mehr proteinkodierende Gene (Millionen) als die "menschlichen" Zellen, die etwas mehr als 20.000 proteinkodierende Gene enthalten, die auf zwei Paaren von 23 Chromosomen verteilt sind. Das Darmmikrobiom erstreckt sich von der Speiseröhre bis zum unteren Darm. Diese Darmbakterien interagieren mit dem zentralen, autonomen und peripheren Nervensystem als Teil der Mikrobiota-Darm-Hirn-Achse. Darüber hinaus gibt es auch Neuronen im Darm oder im enterischen System. Diese werden als enterisches Nervensystem (ENS) bezeichnet.
Das ENS ist ein separater Zweig des autonomen Nervensystems. Das ENS erstreckt sich über die gesamte Länge des Magen-Darm-Trakts (GIT). Der GIT wird von einem Netz von 200-600 Millionen Neuronen dicht innerviert. Diese Neuronen innervieren alle Regionen des GIT. Das ENS beeinflusst die Physiologie und Funktion des GIT und kommuniziert mit dem Zentralnervensystem (ZNS) sowohl über parasympathische als auch sympathisch-vagale Bahnen. Manchmal wird das ENS als unser zweites Gehirn bezeichnet, weil es viele Arten von Neuronen und Gliazellen enthält, die in komplexen Schaltkreisen miteinander verbunden sind, ähnlich wie das Gehirn in unserem Schädel. Das ENS reguliert viele Systeme im Darm und koordiniert die Verdauungs- und Abwehrfunktionen des Darms. Defekte in seiner Entwicklung in der Gebärmutter und/oder Folgeschäden nach der Geburt können Erbrechen, Bauchschmerzen, Verstopfung, das Reizdarmsyndrom (IBS), Morbus Hirschsprung, Wachstumsstörungen und frühen Tod verursachen.
Gleichzeitig produziert das ENS nach der Geburt und im Erwachsenenalter neue Neuronen und beeinflusst so unsere Gesundheit und unser Verhalten während des gesamten Lebens. Viele der enterischen Neuronen leiten sensorische Informationen aus dem Darm an das zentrale Nervensystem (ZNS) weiter. Enterische Gliazellen sind ebenfalls wichtig für das ENS. Wie die Gliazellen im ZNS wurden auch die enterischen Gliazellen ursprünglich nur als unterstützende Zellen angesehen, doch inzwischen ist bekannt, dass sie aktiv am ENS beteiligt sind. Sie verbinden enterische Nerven, enteroendokrine Zellen, Immunzellen und Epithelzellen. Enterische Gliazellen sind auch ein Bindeglied zwischen dem Nerven- und dem Immunsystem und spielen eine wichtige Rolle bei gastrointestinalen Störungen.
Die Wechselwirkungen gehen in beide Richtungen in einem bidirektionalen Kommunikationsnetz, das das ENS mit dem ZNS und dem übrigen neuroendokrinen Nervensystem verbindet. Dieses Netzwerk verbindet die emotionalen und kognitiven Zentren des Gehirns über das neuronale, endokrine und immunologische System mit den Funktionen des Darms. Unser Darmmikrobiom beeinflusst unser Verhalten, unsere Gesundheit, unsere Intelligenz und unsere Gefühle. Die Zusammensetzung der Bakterien in unserem Darm ist nicht fest verdrahtet. Sie hängt davon ab, was unsere Mütter essen, wenn wir im Mutterleib sind, und was wir nach der Geburt essen, sowie von unserer Exposition gegenüber Antibiotika. Unsere Intelligenz und unser Verhalten können sich durch Training, Erziehung, Belastung durch Umweltgifte und sogar durch unsere Ernährung (die unser Darmmikrobiom beeinflusst) verändern.
Eine Dysbiose in der Darm-Mikrobiota-Darm-Hirn-Achse spielt eine wichtige Rolle bei abweichendem Sozialverhalten sowie bei der Entstehung verschiedener neurodegenerativer Erkrankungen, darunter Angstzustände, Depressionen, Autismus und die Parkinsonsche Krankheit. Neurodegenerative Erkrankungen können sich durchaus auf die Intelligenz und die Emotionen eines Menschen auswirken, die nicht in unseren Genen verankert sind. Das Darmmikrobiom und das ENS spielen auch eine wichtige Rolle bei der Aufrechterhaltung der Homöostase und der Energieproduktion sowie bei der Beeinflussung von Fettleibigkeit. Infolgedessen ist das ENS auch ein wichtiger Faktor bei Diabetes, entzündlichen Erkrankungen, Darmkrebs, chronischen Nierenerkrankungen, Atherosklerose und Herzerkrankungen. Die menschliche Darmmikrobiota produziert auch Melatonin, das dazu beiträgt, dass der Darm eine zirkadiane Rhythmik aufweist (der 24-Stunden-Zyklus, der den Schlaf und viele physiologische Prozesse beeinflusst).
Die Darmmikrobiota und das ENS können als entero-endokrines Organ betrachtet werden, das über viel mehr Zellen und proteinkodierende DNA verfügt als der Rest des menschlichen Körpers. Der GIT ist ein wichtiger Knotenpunkt im Kommunikationsnetz des menschlichen Körpers. Es enthält die höchste Konzentration von Immunzellen im Körper. Es handelt sich um ein Netzwerk aus 200-600 Millionen Neuronen und Billionen von Viren, Bakterien, Archaeen und Eukaryonten, die die menschliche Darmmikrobiota bilden. Das Darmmikrobiom trägt zur Regulierung der Darmfunktion bei und interagiert mit dem Rest des Körpers, um eine gute Gesundheit zu erhalten. Die Darmmikrobiota ist wie ein Leiter der Kommunikation zwischen dem Immunsystem und dem neuroendokrinen Netzwerk. Das heißt, die Mikrobiota produziert und sezerniert Hormone, reagiert auf Hormone, die von menschlichen eukaryotischen Zellen sezerniert werden, und reguliert deren Expression.
Viele der Biosynthesewege, die neuroendokrine Hormone produzieren, finden sich sowohl in Bakterien als auch in menschlichen eukaryotischen Zellen. Die Darmmikrobiota produziert also Neurohormone, die als Reaktion auf einen neuronalen Input ausgeschüttet werden, und reagiert darauf. Die Mikrobiota kann das Verhalten durch Neurohormone wie Serotonin, Dopamin und Noradrenalin modulieren. Gleichzeitig können diese Neurohormone das Wachstum, die Motilität, die Biofilmbildung und/oder die Virulenz von Bakterien verändern. Serotonin ist zwar ein wichtiger Neurotransmitter im Gehirn, befindet sich aber zu 90 % in den Därmen. Es ist ein wichtiges Signalmolekül sowohl im Darm als auch im Gehirn. Darüber hinaus arbeiten die Mikrobiota, Hormone und die menschlichen eukaryotischen Zellen zusammen, um ein gesundes Immunsystem aufrechtzuerhalten.
Ernährung, Bewegung, Stimmung, allgemeiner Gesundheitszustand, Stress und Geschlecht können die Konzentrationen von Hormonen verändern, die das Darmmikrobiom beeinflussen können. Auch das Gegenteil ist der Fall. Eine gesunde Darmmikrobiota kann dazu beitragen, eine Person ruhig zu halten, da die Bakterien die Konzentrationen von Stresshormonen (Corticosteron und adrenocorticotropes Hormon) beeinflussen. Andererseits kann eine Dysbiose im Darmmikrobiom zu Autoimmunkrankheiten, einschließlich Typ-1-Diabetes, beitragen. Diese Form der Kommunikation zwischen den Organismen wurde als mikrobielle Endokrinologie bezeichnet. So kann beispielsweise die stressvermittelte Ausscheidung von Neurohormonen die Expression von Genen in pathogenen Bakterien im Darm verändern. Hormone und Neurotransmitter wirken sich auf viele Aspekte des Verhaltens aus, das nicht nur im Gehirn im Schädel fest verdrahtet ist.
Unsere Gesundheit und unser Verhalten hängen zum Teil auch vom Darmmikrobiom ab - unserem zweiten Gehirn. Folglich werden unser Verhalten und unsere geistigen Fähigkeiten durch unseren Lebensstil, unsere Ernährung und den Kontakt mit Antibiotika beeinflusst. Sie sind nicht durch die Gene, die wir bei der Empfängnis erben, fest verdrahtet. Wenn jedoch viele Autoren über die Anzahl der verschiedenen Arten menschlicher Zellen schreiben, beziehen sie sich auf die menschlichen eukaryotischen Zellen3-4. Noch im Jahr 2023 wurde die Zahl der menschlichen Zelltypen bei Erwachsenen und Kindern auf etwas mehr als 400 geschätzt, aber mindestens eine Quelle geht von etwa 1200 Zellgruppen aus 5. Es wurde auch geschätzt, dass ein 70 kg schwerer Mann insgesamt 36 Billionen Zellen hat, eine 60 kg schwere Frau 28 Billionen und ein 10-jähriges Kind, das 32 kg wiegt, 17 Billionen.
Es gibt sogar einen menschlichen Zellatlas, ein internationales Projekt zur Erstellung eines umfassenden Referenzatlasses von Zellen in allen Organen, Geweben und Systemen des menschlichen Körpers6. Bis vor kurzem wurden Zelltypen anhand der Morphologie und anderer Faktoren identifiziert. Für die Analyse solcher Gruppen war es notwendig, viele Zellen zu erhalten. Dies zwang die Forscher dazu, die durchschnittlichen Eigenschaften solcher Zellen zu messen. Es wurden die durchschnittlichen Aktivitäten und Mengen vieler Proteine bestimmt. Dies beruhte zum Teil auf dem zentralen Dogma der Molekularbiologie: Die DNA kodiert für die RNA, die wiederum für die Proteine kodiert, welche die wichtige Arbeit in den Zellen verrichten. Das heißt, die Information fließt von der DNA über die RNA zu den Proteinen. Die DNA galt als die Blaupause des Lebens.
Wir haben jedoch seit vielen Jahrzehnten erkannt, dass das zentrale Dogma falsch ist. Es gibt eine riesige Ebene der Kontrolle, die über der Genetik liegt. Sie wird Epigenetik genannt. Das heißt, unsere Zellen müssen in der Lage sein, angemessen auf die sich ständig ändernden Bedürfnisse des Organismus zu reagieren, wenn er mit der Umwelt interagiert. Die Gene müssen von der Empfängnis über die Trächtigkeit, die Entwicklung und alle Lebenszyklen hinweg zu geeigneten Zeitpunkten ein- und ausgeschaltet werden. Die Transkription von Genen in RNA wird also durch epigenetische Veränderungen gesteuert. Dinge wie Zucker, Lipide, Phosphate, Methyl- und Acetylgruppen können der DNA und den Proteinen hinzugefügt werden, um die Transkription zu steuern. Auch die Übersetzung von Boten-RNA in Proteine kann durch epigenetische Veränderungen gesteuert werden. Es gibt noch viele andere Arten von RNA, wie z. B. die Mikro-RNA (miRNA), die zur Regulierung der Translation beiträgt.
Bis vor kurzem konnte jedoch nur der Durchschnitt der Arten und Mengen epigenetischer Veränderungen gemessen werden. Technologische Fortschritte haben es den Wissenschaftlern ermöglicht, einzelne Zellen genau zu untersuchen. Wir können die Menge und Art der RNA- und Proteinmoleküle, die eine einzelne Zelle produziert, quantifizieren. Darüber hinaus können wir sehr empfindliche Nachweismethoden verwenden, die es uns ermöglichen, viel mehr Proteine und RNA-Moleküle zu quantifizieren, auch solche, die in geringen Konzentrationen vorhanden sind. Viele der Schlüsselproteine und RNA, die den Stoffwechsel steuern, sind in geringen Konzentrationen vorhanden. Neue Technologien ermöglichen es uns daher, mehr zu sehen und kleine Unterschiede zu erkennen. Eine dieser Techniken ist die Einzelzell-Flüssigkeitschromatographie, gekoppelt mit Massenspektrometrie (ezLC-MS)7-9. Das heißt, eine einzelne Zelle wird entnommen und verarbeitet, um eine wässrige Lösung herzustellen, die Proteine und RNA enthält.
Die wässrige Lösung wird auf eine Säule gespritzt, die mit Material gefüllt ist, das es ermöglicht, die vielen Arten von Proteinen und RNA voneinander zu trennen. Wenn jedes Peptid-, Protein- und RNA-Molekül von der Säule gewaschen wird, gelangt es in ein Massenspektrometer, das ihre Masse und relative Häufigkeit misst. Auf diese Weise kann der Analytiker die Proteine (das Proteom) und die RNA, die von der DNA transkribiert wird (das Transkriptom), messen. So wurden mit ezLC-MS menschliche Gehirnzellen analysiert und detaillierte Zellkarten erstellt, die detaillierter sind als bisher10-11. Es kann Tausende von Proteinen, Proteoformen und posttranslationale Veränderungen in einzelnen Zellen nachweisen und quantifizieren. Mehr als 3000 verschiedene Arten von Gehirnzellen wurden von einem Forscherkonsortium identifiziert.
Das Projekt war Teil der laufenden Bemühungen, das menschliche Gehirn und seine Natur zu verstehen. Das Konsortium wurde im Rahmen der BRAIN-Initiative (Brain Research Through Advancing Innovative Neurotechnologies®) der National Institutes of Health zusammengestellt und finanziert. Wissenschaftler aus aller Welt untersuchten den zellulären Aufbau des menschlichen Gehirns und anderer Primaten. Sie untersuchten die detaillierte Organisation des menschlichen Gehirns in einem noch nie dagewesenen Ausmaß. Die Gehirne von Säugetieren bestehen aus Milliarden von Neuronen und Gliazellen, die hochkomplexe Verhaltensweisen aufweisen. Diese Zellen sind in mehrere große funktionelle Regionen mit unterschiedlichen Entwicklungsursprüngen unterteilt. Jeder Hirnbereich enthält eine bestimmte Anzahl von Zelltypen, einschließlich Neuronen und Gliazellen. Der Hirnstamm verfügt über sehr unterschiedliche Neuronen, die angeborene Verhaltensweisen unterstützen können.
Sie untersuchten die Variabilität der Gehirnzelltypen zwischen einzelnen Menschen. Sie fanden heraus, dass wir alle die gleichen Arten von Gehirnzellen haben, deren Anteile jedoch von Mensch zu Mensch erheblich variieren. Außerdem verglichen sie die menschlichen Gehirnzelltypen mit denen von Schimpansen und Gorillas (unseren nächsten Verwandten). Sie fanden heraus, dass wir dieselbe grundlegende Architektur der Gehirnzellen haben wie unsere engen evolutionären Vettern. Allerdings gibt es Veränderungen bei den Genen, die von diesen konservierten Zelltypen verwendet werden. Wichtig ist, dass viele Gene, die an den Verbindungen zwischen Neuronen und der Bildung von Schaltkreisen im Gehirn beteiligt sind, bei Menschen und diesen Primaten unterschiedlich sind. Sie verglichen auch die Zellen in verschiedenen Regionen der Großhirnrinde, die viele unserer fortgeschrittensten kognitiven Funktionen steuert.
Sie untersuchten die Eigenschaften der hemmenden Neuronen im menschlichen Neokortex, einschließlich ihrer elektrischen Eigenschaften und ihrer komplexen 3D-Formen, sowie die Gene, die transkribiert werden. Die gewonnenen Informationen helfen uns nicht nur zu verstehen, wie gesunde Gehirne funktionieren, sondern auch, die Ursachen von neurodegenerativen Krankheiten und Störungen zu finden. Dies könnte letztlich zu besseren Behandlungen und sogar Heilungsmöglichkeiten führen. In der nächsten Phase der Forschung werden mit Hilfe des Zellatlas-Netzwerks der BRAIN-Initiative (BICAN) viel umfassendere Atlanten der Gehirne von Menschen und anderen Primaten erstellt. In der Zwischenzeit haben andere Wissenschaftler vor kurzem den Teil des Gehirns untersucht, der als kaudaler Nukleus des Solitärtrakts (kNST) bezeichnet wird12-13. Es ist ein Teil des Hirnstamms, der dem Gehirn hilft, mit dem Rest des Körpers zu kommunizieren.
Das kNST ist das primäre Ziel des Vagusnervs, der das Gehirn in unserem Kopf mit dem Gehirn in unserem Darm (dem enterischen Nervensystem) verbindet. Sie identifizierten spezifische Gruppen von Neuronen innerhalb des kNST und des Vagusnervs, die dabei helfen, Entzündungen zu erkennen und zu kontrollieren. Das kNST wirkt wie ein Thermostat für das Immunsystem und trägt dazu bei, eine ausgewogene Reaktion auf Entzündungen aufrechtzuerhalten. Die Forscher fanden spezifische Neuronen im Vagusnerv und im kNST, die Entzündungen erkennen und kontrollieren. Diese Neuronen reagieren auf verschiedene Immunsignale, darunter entzündungsfördernde und entzündungshemmende Zytokine. Dies könnte die Art und Weise revolutionieren, wie wir eine Reihe von immunbezogenen Krankheiten behandeln.
Erkrankungen wie rheumatoide Arthritis, multiple Sklerose und entzündliche Darmerkrankungen, die derzeit zwar behandelt, aber nicht geheilt werden, könnten von Therapien profitieren, die auf die Kontrolle des Gehirns über Entzündungen abzielen. Diese Entdeckung könnte auch zu neuen Behandlungen für akute Entzündungszustände führen, wie z. B. die schweren Immunreaktionen, die bei einigen Virusinfektionen, einschließlich COVID-19, auftreten. Die Möglichkeit, das Immunsystem über das Gehirn zu modulieren, eröffnet neue Möglichkeiten für die medizinische Behandlung und gibt Hoffnung auf eine bessere Behandlung und vielleicht sogar Heilung von chronischen und akuten Entzündungskrankheiten. Die Analyse einzelner Zellen kann auch wichtige Informationen über das Immunsystem liefern, das für eine gute Gesundheit im Gleichgewicht gehalten werden muss. Eine gewisse Aktivität ist notwendig, um Infektionen abzuwehren und Wunden zu heilen.
Ein überaktives Immunsystem kann jedoch Autoimmunkrankheiten wie das Reizdarmsyndrom verursachen. Daher untersuchten die Forscher mithilfe der Einzelzell-RNA-Sequenzierung die Auswirkungen von Interleukin-23 (IL-23) auf verschiedene Arten von Immunzellen im gesunden Darm. Es interagiert mit den angeborenen lymphoiden Zellen der Gruppe 3 (ILC3), einer Familie von Immunzellen, die eine erste Verteidigungslinie in Schleimhautgeweben wie dem Darm und der Lunge bilden. Als Reaktion darauf erhöhen die ILC3 die biologischen Aktivitäten der nützlichen Darmmikrobiota und des zytotoxischen T-Lymphozyten-assoziierten Proteins Nummer 4 (CTLA-4). Dabei handelt es sich um einen Regulationsfaktor, der verhindert, dass das Immunsystem den Körper angreift. Diese Interaktion gleicht die entzündungsfördernden Wirkungen von IL-23 aus, um die Darmgesundheit zu erhalten, ist aber bei Reizdarmsyndrom beeinträchtigt. ILC3s ist also ein wichtiges Bindeglied zwischen den proinflammatorischen Wirkungen von IL-23 im Darm.
Es bleibt zu hoffen, dass weitere Forschungen zu diesem Signalweg uns helfen werden, Krebs zu bekämpfen und eine schwerwiegende Nebenwirkung der Krebsimmuntherapie zu lindern. Auch unser Immunsystem ist für den Alterungsprozess sehr wichtig. Ein richtiges Gleichgewicht kann die biologische Alterung verlangsamen. Ein unausgewogenes Immunsystem kann den Alterungsprozess beschleunigen. Dies geschieht durch epigenetische Veränderungen, die zur Schätzung des biologischen Alters herangezogen werden können. In einer kürzlich durchgeführten Studie wurde beschrieben, wie Immunzellprofile mit Schätzungen des biologischen Alters auf der Grundlage epigenetischer Uhren zusammenhängen13. Sie berechneten eine intrinsische epigenetische Altersbeschleunigung (Intrinsic Epigenetic Age Acceleration, IEAA), die ein besseres Verständnis des Alterungsprozesses auf zellulärer Ebene ermöglicht.
Sie verbesserten unser Verständnis der epigenetischen Uhr, indem sie zeigten, wie verschiedene Untergruppen von Immunzellen zur epigenetischen Alterung beitragen. Das Epigenom ist also mindestens so wichtig wie das Genom (die DNA in unseren 23 Chromosomenpaaren). Es gibt viele Arten von -omics, darunter Epigenomics, Transcriptomics, Proteomics, Lipidomics, Metabolomics und Glycomics, sowie Exposomics. Dabei handelt es sich um die Erfassung aller epigenetischen Veränderungen, Transkriptionsprodukte, Proteine, Lipide, Metaboliten und Glykane (Kohlenhydrate) in einer Zelle oder einem Organismus sowie der Auswirkungen der Exposition gegenüber Umweltchemikalien. Einzelzell-Multiomik-Technologien revolutionieren die Krebsforschung14. Es ist jetzt möglich, die Heterogenität innerhalb von Tumoren zu entdecken und die einzigartigen molekularen Merkmale verschiedener Zellpopulationen zu verstehen.
Wir können seltene Subpopulationen von Zellen identifizieren, die für das Tumorwachstum, die Metastasierung und die Therapieresistenz von Bedeutung sind. Wir lernen auch mehr über die Immunantwort auf verschiedene Therapien. Dazu gehören die Immun-Checkpoint-Blockade, die Chemotherapie und die Zelltherapie. Wir erfahren auch viel mehr über die Mikroumgebung des Tumors und deren Einfluss auf die Prognose und das Ansprechen auf die Behandlung. Dieser interdisziplinäre Ansatz zielt darauf ab, das komplizierte Zusammenspiel zwischen Genomik, Epigenomik und anderen -omik zu beschreiben. Dieser interdisziplinäre Ansatz ist ganzheitlich. Er hilft uns, die zelluläre Entwicklung, die Pathogenese und andere grundlegende biologische Prozesse zu verstehen. Dank der Fortschritte bei der Sequenzierung der nächsten Generation und der Massenspektrometrie erfahren wir, wie das Transkriptom, das Methylom, das Proteom, die posttranslationalen Histonmodifikationen und das Mikrobiom Gesundheit und Krankheiten beeinflussen.
So wurde beispielsweise vor kurzem ein Atlas der Epithelzellzustände und der Plastizität bei Lungenadenokarzinomen erstellt15. Er hilft uns, die zellulären Prozesse zu verstehen, die am frühen Lungenadenokarzinom (LUAD) beteiligt sind. Sie untersuchten 246.102 einzelne Epithelzellen aus 16 LUADs im Frühstadium und 47 vergleichbaren normalen Lungenproben. Es zeigte sich, dass Epithelzellen, die eine kritische Mutation in einem Gen namens KRAS aufweisen, Vorläufer von Krebszellen in der Lunge sind. Dies lieferte neue Erkenntnisse über den Zustand der Epithelzellen, der der Entstehung von LUAD zugrunde liegt. Einige dieser Zustände könnten potenzielle Angriffspunkte für die Vorbeugung oder Heilung von LUAD bieten.
In einer anderen Studie wurde die Heterogenität von Bauchspeicheldrüsenkrebszellen mit Hilfe der Einzelzell-RNA-Analyse und der räumlichen Transkriptomik untersucht16. Das duktale Adenokarzinom der Bauchspeicheldrüse (PDAC) ist eine sehr tödliche Krebsart. Es hat eine heterogene genetische Landschaft und eine immunsuppressive Tumormikroumgebung. Die Forscher untersuchten sowohl die bösartigen als auch die Wirtszelltypen. Sie erfuhren mehr über die Heterogenität und Plastizität von PDAC während der Therapie. Wir werden also weiterhin die vielen Zelltypen im menschlichen Körper untersuchen. Dazu gehören bakterielle Zellen in unserem Darm, gesunde menschliche eukaryotische Zellen und die große Vielfalt von Krebszellen.
Anmerkungen
1 Smith, R.E. Ballaststoffe, das Darmmikrobiom und Gesundheit. Es gibt eine unbestreitbare Verbindung zwischen dem Gehirn, dem Darm und dem Immunsystem. Meer, 9 March, 2023.
2 Smith, R.E. Unser zweites Gehirn. Das enterische Nervensystem und das Darmmikrobiom. Meer, 20 Jan., 2023.
3 Murugesu, J.A. We now know how many cells there are in the human body, New Scientist.
4 Mostafa, H.K.K. Different cells of the human body: Categories and morphological characters, Journal of Microscopy and Ultrastructure.
5 Hatton, I.A., et al. The human cell count and size distribution, Proceedings of the National Academy of Sciences.
6 Human Cell Atlas, 2024.
7 Single cell proteomics, ThermoFisher Scientific.
8 Ye, X. et al. Combination of automated sample preparation and micro-flow LC–MS for high-throughput plasma proteomics, Clinical Proteomics.
9 Zheng, R. et al. A high-sensitivity low-nanoflow LC-MS configuration for high-throughput sample-limited proteomics, Analytical Chemistry.
10 Tompa, R. What makes us human? Detailed cellular maps of the entire human brain reveal clues, Allen Institute.
11 Siletti, K. et al. Transcriptomic diversity of cell types across the adult human brain, Science.
12 Jin, H. et al. A body–brain circuit that regulates body inflammatory responses, Nature.
13 Zhang, Z. et al. Deciphering the role of immune cell composition in epigenetic age acceleration: Insights from cell‐type deconvolution applied to human blood epigenetic clocks, Aging Cell.
14 Liang, A. et al. Advancements and applications of single-cell multi-omics techniques in cancer research: Unveiling heterogeneity and paving the way for precision therapeutics, Biochemistry and Biophysics Reports.
15 Han, G. et al. An atlas of epithelial cell states and plasticity in lung adenocarcinoma, Nature.
16 Bärthel, Stefanie, et al. Single-cell profiling to explore pancreatic cancer heterogeneity, plasticity and response to therapy, Nature Cancer.